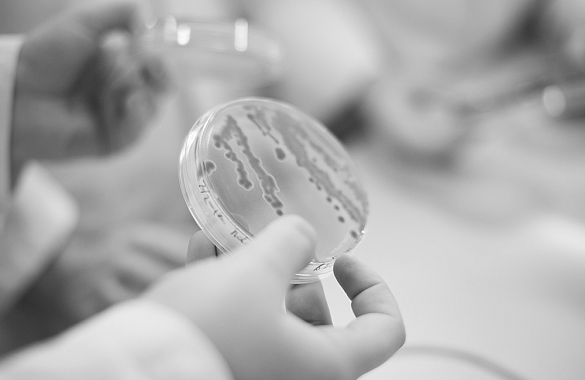

Efteruddannelse og kurser
Styrk dine faglige kompetencer med en efteruddannelse fra Erhvervsakademi MidtVest
Efteruddannelse er din mulighed for at styrke dine faglige kompetencer indenfor dit fagområde, eller tilegne dig helt nye færdigheder, som kan få dig videre i karrieren. Hos Erhvervsakademi MidtVest tilbyder vi hele 18 forskellige efteruddannelser og endnu flere kurser indenfor flere forskellige fagområder. Vores kurser udbydes primært i Herning og Holstebro, enkelte også i Skjern.
Vi tilbyder kurser og efteruddannelse indenfor Ledelse, Salg og marketing, It og kommunikation, Teknologi og produktion samt Laboratorie, fødevare, ernæring og sundhed.